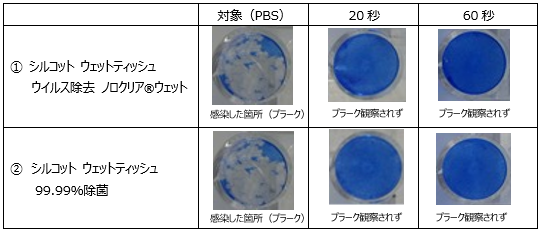

2021年03月25日
ユニ・チャームと北里大学が新型コロナウイルス抑制を
シルコット ウェットティッシュ『ウイルス除去 ノロクリア®ウエット』『99.99%除菌』で実証
ユニ・チャーム株式会社(本社:東京都港区、代表取締役 社長執行役員:高原豪久、以下当社)は、学校法人北里研究所 北里大学医療衛生学部への委託研究により、シルコット ウェットティッシュ『ウイルス除去 ノロクリア®ウェット』『99.99%除菌』のウェットシートを絞った液体が、新型コロナウイルスを抑制することを実証できましたのでお知らせします。
対物専用ウェットティッシュ


シルコット ウェットティッシュ
『ウイルス除去 ノロクリア®ウェット』『99.99%除菌』
研究結果のまとめ
以下の表でも示す通り、2つの評価方法((1)TCID50法と(2)プラーク法)で、試験サンプル①、②ともに、新型コロナウイルスに対して抑制効果を認め、20秒の混和処理で99.99%以上の抑制率を示した。


(1)TCID50(50% Tissue Culture Infectious Dose)法とは、細胞を96穴開いたプレートに培養し、ウイルスを含んだ液を複数の希釈濃度に調整して細胞へ接種し,半分の細胞が変性する濃度を測定する試験を示す。
(2)プラーク法とは、シート状に培養した培養細胞にウイルスを含んだ液に接種したあと、全体を寒天培地などで被い培養します。その後、ウイルスの感染が隣り合った細胞のみに限定されて拡大するため、一定時間経過後には感染した箇所(プラーク)を肉眼で測定する試験を示す。
研究の背景
新型コロナウイルス感染拡大に伴い、身の回りで触れる物に対する衛生意識が高まっています。特に公共の場で不特定多数の方が触れるスイッチやドアノブ・テーブルなどに対して、手軽に感染予防ができるアイテムとしてウェットティッシュの使用習慣も定着しています。
そこで、当社と北里大学医療衛生学部との委託研究で、シルコットウェットのウェットシートを絞った液体を用いて新型コロナウイルスの抑制効果を検証しました。
研究の概略
北里大学医療衛生学部において、市場に流通している当社のシルコット ウェットティッシュ『ウイルス除去ノロクリア®ウェット』『99.99%除菌』において、新型コロナウイルス抑制試験を検証し、その効果を実証しました。
(試験サンプル(2種共にウェットシートを絞った液体))
①シルコット ウェットティッシュ ウイルス除去 ノロクリア®ウェット
[成分]:エタノール,ベンザルコニウムクロリド,変形リゾチーム
②シルコット ウェットティッシュ 99.99%除菌
[成分]:エタノール,ベンザルコニウムクコロリド
(試験条件と試験方法)
Step①:新型コロナウイルス「SARS-CoV-2(Virus: 2 x 107 pfu/ml)」を使い、宿主細胞には「VeroE6/TMPRSS2」、ウイルス培養時の培地は「DMEM」を用いた。
Step②:ウイルスを含んだ液(2 x 107pfu/ml)と試験対象液(ウェットシートを絞った液体)を各1:9の割合で混合させ、室温で20秒、60秒間、ウイルス液と反応させた。希釈用培地にて10倍希釈系列を調整し、TCID50 法とプラーク法によりそれぞれ抗ウイルス価を測定した。




研究の結果
(1)TCID50 法による「シルコットウェット」ウェットシートを絞った液体ウイルス抑制率を検証
※TCID50法(50% Tissue Culture Infectious Dose): ウイルス感染による細胞死の有無を判定
20秒, 60秒処理共にほぼ完全な抑制効果が認められた。抑制率は99.99%以上を実証。


(2)プラーク法による「シルコットウェット」ウェットシートを絞った液体ウイルス抑制率を検証
※プラーク法:ウイルス感染による細胞死をプラーク形成の有無で判定
20秒, 60秒処理共にほぼ完全な抑制効果が認められた。抑制率は99.99%以上を実証。

シルコット ウェット ホームページ
『シルコットウェット』で新型コロナウイルス抑制の実証を通じて貢献する「SDGs 17の目標」
『シルコットウェット』で新型コロナウイルス抑制の実証は、2015年に国連で採択された「持続可能な開発目標」(SDGs:Sustainable Development Goals)で定めた17の目標のうち、下記の2つに貢献するとユニ・チャームでは考えております。
3.すべての人に健康と福祉を 12. つくる責任 つかう責任
ユニ・チャームは商品やサービスの提供といった事業活動を通じて、SDGsの目標達成に貢献することを目指しています。これからも事業活動の展開を通じて、環境保護や社会課題の解決に貢献します。
<<本件に関するお問い合わせ先>>
一般報道機関の方は、ユニ・チャーム(株)企画本部広報室 TEL:03-6722-1019
流通業界紙・誌の方は、ユニ・チャーム(株)流通戦略統括部 TEL:03-6722-1007
消費者の方は、ユニ・チャーム(株)お客様相談センター TEL:0120-573-001
